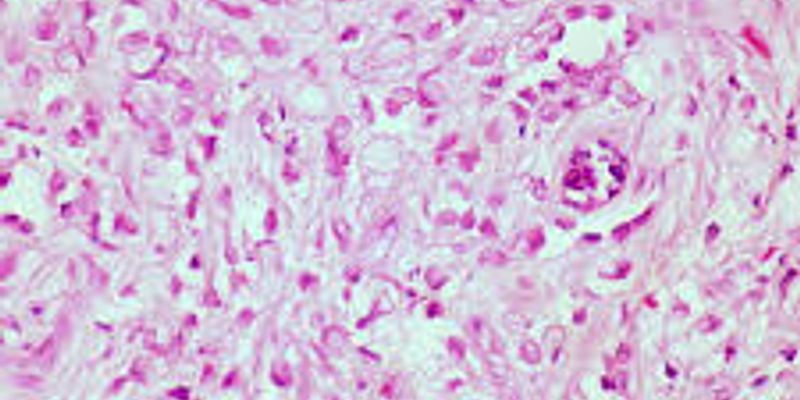

Carcinoma
Carcinoma: is a type of cancer that starts in cells that make up the skin or the tissue lining organs, such as the liver or kidneys. Like other types of cancer, carcinomas are abnormal cells that divide without control. They are able to spread to other parts of the body, but don't always.
What's Popular in Carcinoma
-
DEC 30, 2025CancerVitamin B3, or niacin, is essential in small amounts for normal body function. The skin, nerves, and digestive system al ...Written By: Katie KokolusDEC 02, 2025CancerRecent findings published in Scientific Reports highlight a promising target for ovarian cancer drug development, emphas ...Written By: Katie KokolusSEP 22, 2025CancerOur bodies require nicotinamide, a form of vitamin B3 (also known as niacin), in small quantities, for regular functions ...Written By: Katie KokolusJUL 31, 2025CancerA case report recently published in the New England Journal of Medicine (NEJM) presents a previously unknown cause of sk ...Written By: Katie KokolusJUL 07, 2025CancerNasopharyngeal carcinoma (NPC), a malignancy that develops in the upper section of the throat behind the nose, occurs in ...Written By: Katie Kokolus
DEC 30, 2025
Cancer
Vitamin B3, or niacin, is essential in small amounts for normal body function. The skin, nerves, and digestive system al
...
Written By:
Katie Kokolus
DEC 02, 2025
Cancer
Recent findings published in Scientific Reports highlight a promising target for ovarian cancer drug development, emphas
...
Written By:
Katie Kokolus
SEP 22, 2025
Cancer
Our bodies require nicotinamide, a form of vitamin B3 (also known as niacin), in small quantities, for regular functions
...
Written By:
Katie Kokolus
JUL 31, 2025
Cancer
A case report recently published in the New England Journal of Medicine (NEJM) presents a previously unknown cause of sk
...
Written By:
Katie Kokolus
JUL 07, 2025
Cancer
Nasopharyngeal carcinoma (NPC), a malignancy that develops in the upper section of the throat behind the nose, occurs in
...
Written By:
Katie Kokolus
APR 09, 2025
Plants & Animals
A systematic review published in Discover Oncology explores the anticancer efficacy of medicinal plant extracts in treat
...
Written By:
Greta Anne
FEB 06, 2025
Immunology
The advent of vaccinations came when a scientist, by the name of Edward Jenner, discovered that an individual exposed to
...
Written By:
Brian G. Morreale
JAN 18, 2025
Cancer
Biliary tract cancer (BTC), a rare malignancy that grows within the bile ducts and gallbladder, grows very aggressively.
...
Written By:
Katie Kokolus
DEC 24, 2024
Cancer
Peppermint, a delightful species of mint born from the union of watermint and spearmint, has been gracing our winters wi
...
Written By:
Katie Kokolus
-
NOV 18, 2025 | 10:00 AMPerineural invasion (PNI) is a well-established factor of poor prognosis in multiple cancer types, yet its mechanism remains unclear. By using a multi-omics approach, overlay of multiple spa...OCT 17, 2025 | 8:00 AMHepatobiliary cancers, including hepatocellular carcinoma (HCC) and gallbladder cancer (GBC), are strongly linked to chronic inflammation. Recent research using the Olink PEA Technology sugg...Sept. 3, 2025 | 10:30am (IST), 1:00pm (SGT), 2:00pm (KST), 3:00pm (AEST), 5:00pm (NZST)Spatial Biology has emerged as the latest discipline with a demonstrably transformative impact on advancing translational research. In particular, spatial proteomics focuses on the localized...MAY 13, 2025 | 9:00 AMImmune checkpoint blockade (ICB) targeting T cells has enhanced clinical outcomes in patients with renal and bladder cancers; however, response rates remain limited, particularly in cases of...In this webinar, discover how Dr El Ahmar utilizes the BOND RX autostainer and image analysis workflow to stain formalin-fixed paraffin-embedded (FFPE) clinical trial samples with multiplex...
NOV 18, 2025 | 10:00 AM
Perineural invasion (PNI) is a well-established factor of poor prognosis in multiple cancer types, yet its mechanism remains unclear. By using a multi-omics approach, overlay of multiple spa...
OCT 17, 2025 | 8:00 AM
Hepatobiliary cancers, including hepatocellular carcinoma (HCC) and gallbladder cancer (GBC), are strongly linked to chronic inflammation. Recent research using the Olink PEA Technology sugg...
Sept. 3, 2025 | 10:30am (IST), 1:00pm (SGT), 2:00pm (KST), 3:00pm (AEST), 5:00pm (NZST)
Spatial Biology has emerged as the latest discipline with a demonstrably transformative impact on advancing translational research. In particular, spatial proteomics focuses on the localized...
MAY 13, 2025 | 9:00 AM
Immune checkpoint blockade (ICB) targeting T cells has enhanced clinical outcomes in patients with renal and bladder cancers; however, response rates remain limited, particularly in cases of...
In this webinar, discover how Dr El Ahmar utilizes the BOND RX autostainer and image analysis workflow to stain formalin-fixed paraffin-embedded (FFPE) clinical trial samples with multiplex...
The 21st Century Cures Act, along with the FDA's Real-World Evidence (RWE) framework, has established a foundation for incorporating real-world data (RWD) into regulatory decision-making...
Speaker:
Dr. Amiee Feiqing Huang
Presented at: Cancer Research & Oncology Virtual Event Series 2024
SEP 12, 2024 | 8:00 AM
Neoantigens are among the newest promising targets for cancer treatment. Unlike tumor-associated antigens, neoantigens are produced only by tumor cells. These unique molecular markers are hi...
MAY 14, 2024 | 9:00 AM
C.E. CREDITS
Survival rates for patients with high grade serous carcinoma of the ovary (HGSC) have stagnated for the past fifty years. Despite the presence of tumor mutations and infiltration of immune c...
In light of the numerous US FDA-approved humanized monoclonal antibodies (mAbs) for cancer immunotherapy, it is surprising that the advancement of B-cell epitope vaccines designed to elicit...
Speaker:
Pravin T.P. Kaumaya, PhD
-
FEB 29, 2024 | 12:00 PM PSTC.E. CREDITSPrecision medicine in solid tumors is transforming the testing and treatment of cancer. You can be part of this exciting field by joining our one-day virtual event. Some of the highlights of...JAN 31, 2023 | 8:00 AM PSTEmpowering Multiplexing Innovation Luminex’s xMAP® Technology enables the evaluation of up to 500 analytes simultaneously in a single well, known as multiplexing. xMAP Technology u...JUN 22, 2022 | 3:00 AM PDTPlease join us for Ion World 2022, a virtual conference that will provide an opportunity to hear from scientists around the world, on how they are advancing research in a broad range of appl...SEP 14, 2021 | 7:00 AM PDTWorking in Tandem : 1st annual TMT Symposia Tandem Mass Tags (TMT) are isobaric labels that allow for simultaneous identification and quantification of protein expression from multiple sampl...SEP 14, 2021 | 12:00 AM PDTEurope - 9:00 AM Central European Summer Time Americas - 9:00 AM Central Daylight Time Asia-Pacific - 9:00 AM Beijing Standard Time (*September 15) ADVANCING SCIENCE: A VIRTUAL IMMUNOLOGY CO...
FEB 29, 2024
| 12:00 PM PST
C.E. CREDITS
Precision medicine in solid tumors is transforming the testing and treatment of cancer. You can be part of this exciting field by joining our one-day virtual event. Some of the highlights of...
JAN 31, 2023
| 8:00 AM PST
Empowering Multiplexing Innovation Luminex’s xMAP® Technology enables the evaluation of up to 500 analytes simultaneously in a single well, known as multiplexing. xMAP Technology u...
JUN 22, 2022
| 3:00 AM PDT
Please join us for Ion World 2022, a virtual conference that will provide an opportunity to hear from scientists around the world, on how they are advancing research in a broad range of appl...
SEP 14, 2021
| 7:00 AM PDT
Working in Tandem : 1st annual TMT Symposia Tandem Mass Tags (TMT) are isobaric labels that allow for simultaneous identification and quantification of protein expression from multiple sampl...
SEP 14, 2021
| 12:00 AM PDT
Europe - 9:00 AM Central European Summer Time Americas - 9:00 AM Central Daylight Time Asia-Pacific - 9:00 AM Beijing Standard Time (*September 15) ADVANCING SCIENCE: A VIRTUAL IMMUNOLOGY CO...
SEP 08, 2021
| 6:00 AM PDT
Luminex's xMAP® Technology enables the evaluation of up to 500 analytes simultaneously in a single well, known as multiplexing. xMAP Technology uses color-coded microspheres as the substrate...
Western blot analysis is a method widely used in the lab today because of its versatility in detecting and measuring specific target proteins in a sample. However, in recent years the reprod...
Each step in a diagnostic test's journey-from raw material extraction to patient administration-can influence outcomes....
10/14-15 9am-1pm CDT
Coming to you from a safe, physical distance, 2020 Abbott World Summit. This event will feature over 15 global experts sharing their latest discoveries and experiences in cancer screening, r...